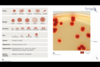
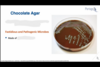
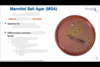
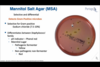

Growth media comes in two forms:
liquid and solid.
The addition of a polysaccharide derived from seaweed (algae) extract creates a solid medium called ______.
Agar
The addition of a ______ extract creates a solid medium called agar.
polysaccharide derived from seaweed (algae)
______ is used to create a solid, smooth surface on which microbes can grow.
Agar
As they grow, microbes form ______ that take on the appearance of individual isolated dots. However, as the microbe increases in number, the isolates merge into one another.
Colonies
Once the microbe has grown to cover the entire plate, this is referred to as a ______.
Lawn
______ is the cousin of Agar.
Gelatin
______ is an animal-derived product that gives Jell-O its classic texture and form.
Gelatin
______ is simply the plant-based form of Gelatin and acts in a very similar way.
Agar
______ is a multi-purpose media capable of growing a wide variety of microorganisms.
LB agar, also known as lysogeny broth
LB agar, also known as lysogeny broth, is a…….
……multi-purpose media capable of growing a wide variety of microorganisms.
LB agar plates are ______ in color as shown in color.
pale yellow
LB is classified as a ___1___ and ___2___ media.
- non-selective
- non-differential
LB agar is commonly used for growing ______, a microbe often associated with molecular microbiology applications based on its ability to easily produce recombinant proteins.
E. Coli
Why is E. coli so commonly used in molecular microbiology applications?
Because of its ability to easily produce recombinant proteins.
What is shown in this picture?

Agar plates. LB agar plates are shown with either the top lid in place (left) or tilted off (right). The agar is melted, sterilized, and poured into a sterile petri dish then allowed to solidify at room temperature.
______ is another multi-purpose media capable of growing a wide variety of microorganisms.TSA plates are virtually identical in color to LB plates. TSA media is non-selective and non-differential and serves as the base when formulating specialized (enriched) medias.
Trypticase soy agar, also known as TSA or TSAYE
Trypticase soy agar, also known as TSA or TSAYE is……
……another multi-purpose media capable of growing a wide variety of microorganisms.TSA plates are virtually identical in color to LB plates. TSA media is non-selective and non-differential and serves as the base when formulating specialized (enriched) medias.
______ serves as the base when formulating specialized (enriched) medias.
Trypticase soy agar, also known as TSA or TSAYE
______ is a derivative of TSA whereby mammalian blood, often from sheep, is added to the plate composition at a concentration range of 5-10%.
Blood agar, also known as BAP (blood agar plates),
Blood agar, also known as BAP (blood agar plates), is a……..
……derivative of TSA whereby mammalian blood, often from sheep, is added to the plate composition at a concentration range of 5-10%.
BAP have a distinct ______ coloration.
red
BAP is an enriched, ___1___ yet ___2___ media.
- non-selective
- differential
The red blood cells in the media promote the growth of ___1___ microorganisms, such as various strains of ___2___.
- fastidious
- Streptococcus